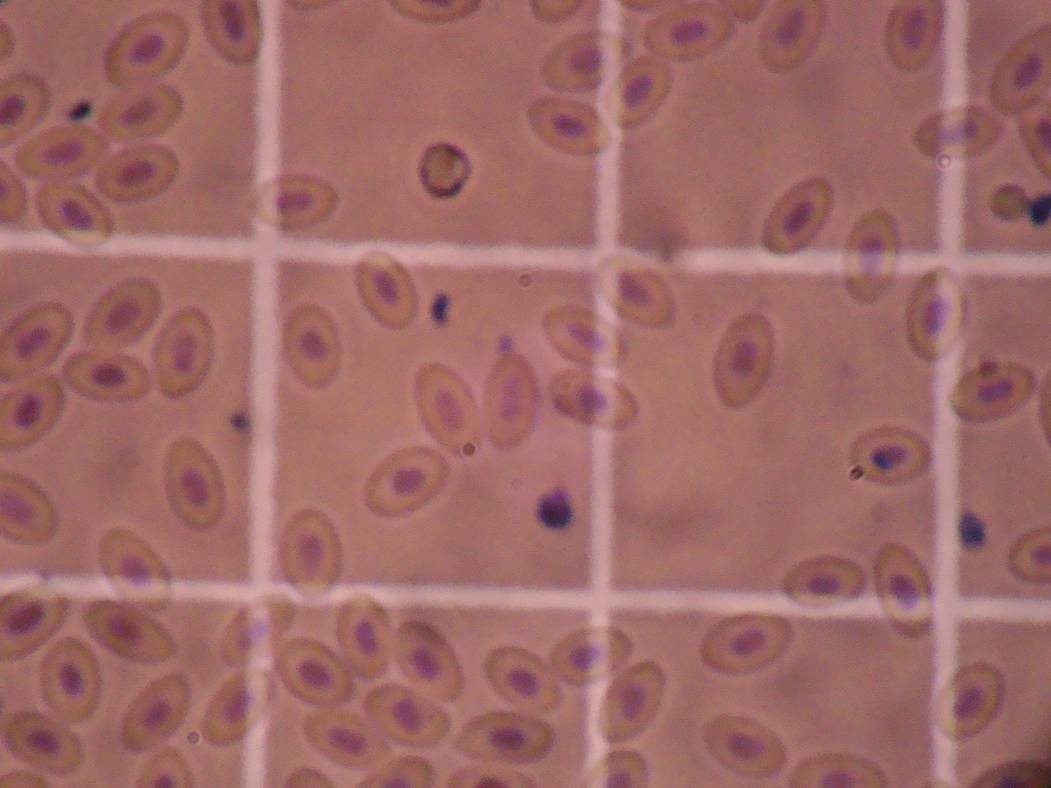
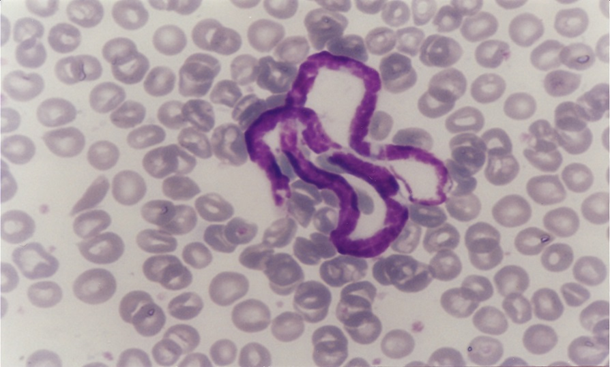

Tuesday 14 April
ISACP Pre-congress workshop
Discovering the universe of Comparative Hematology and Clinical Biochemistry of Exotic Animals
Dr Nicole Stacy and Dr Emma Hooijberg
Diagnostic hematology of exotic animals: lessons from our patients
09:00-10:00 Lecture: Haematology basics
10:00-10:30 Coffee break
10:30-12:00 Practical session: Cases with a focus on birds and reptiles: discussion and blood film evaluation
12:00-13:30 Lunch
Reference intervals for exotics and wild animals
13:30-15:00 Lectures:
• Preanalytical aspects: Sample handling and processing
• Analytical considerations: Species-specific methods, use of point-of-care devices, quality assurance and control
15:00-15:30 Coffee break
15:30-16:30 Lectures:
• Data handling and presentation: Outliers, statistics, partitioning
• Practical application of existing reference interval data: Using published studies as examples
• Panel discussion: challenges, feedback
Tuesday 14 April
ISACP Pre-congress workshop
Discovering the universe of Comparative Hematology and Clinical Biochemistry of Exotic Animals
Dr Nicole Stacy and Dr Emma Hooijberg
Diagnostic hematology of exotic animals: lessons from our patients
09:00-10:00 Lecture: Haematology basics
10:00-10:30 Coffee break
10:30-12:00 Practical session: Cases with a focus on birds and reptiles: discussion and blood film evaluation
12:00-13:30 Lunch
Reference intervals for exotics and wild animals
13:30-15:00 Lectures:
• Preanalytical aspects: Sample handling and processing
• Analytical considerations: Species-specific methods, use of point-of-care devices, quality assurance and control
15:00-15:30 Coffee break
15:30-16:30 Lectures:
• Data handling and presentation: Outliers, statistics, partitioning
• Practical application of existing reference interval data: Using published studies as examples
• Panel discussion: challenges, feedback
*Please note that registration for the Congress automatically includes access to the Pre-Congress Workshop. If you do not plan to attend the ISACP Congress but wish to participate in the Pre-Congress Workshop, you can register here
Lectures by Dr. Nicole Stacy and Dr. Emma Hooijberg

Prof. Emma Hooijberg
BVSc, PhD, Dipl. ECVCP,
Veterinary clinical pathologist,
Nationwide Laboratories,
UK and Extraordinary lecturer,
Faculty of Veterinary Science,
University of Pretoria, South Africa

Dr. Nicole Stacy
Clinical Associate Professor, Aquatic Pathology
Large Animal Clinical Sciences Department,
College of Veterinary Medicine
University of Florida, USA